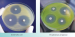
Агар Мюллера-Хинтон II

Агар Мюллера-Хинтон II
Агар Мюллера-Хинтон II сухой
Питательная среда для определения чувствительности микроорганизмов к антибактериальным препаратам диско-диффузионным методом с целью опредления терапевтической схемы лечения инфекционных болезней и характеристики штаммов.
Данный продукт имеет Регистрационное Удостоверение.
Фасовка 250 г для приготовления 7 л среды.
Срок годности 2 года
- Стерильность: -
- Форма выпуска: Порошок
- Упаковка: 250 г
- Документы: Регистрационное Удостоверение